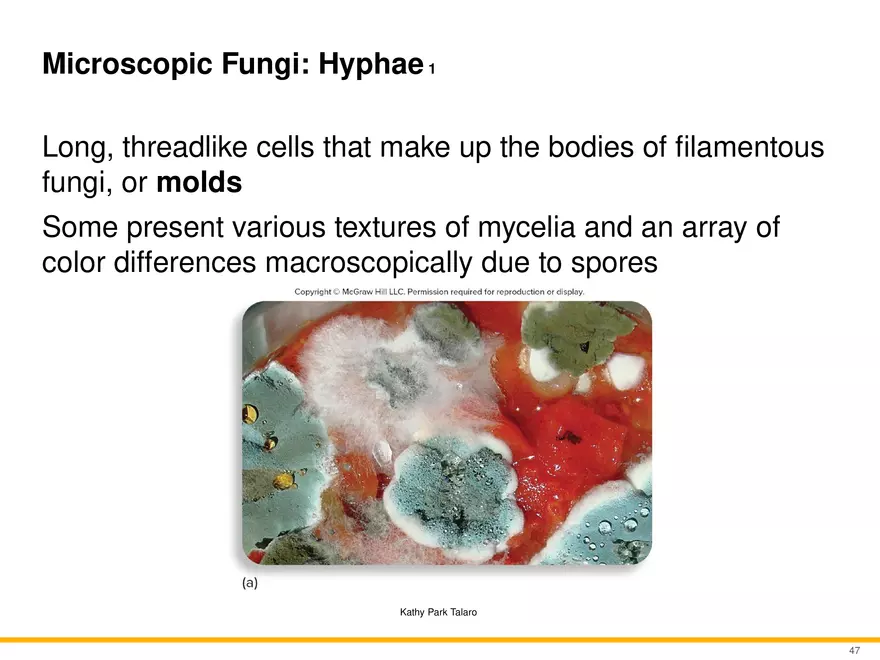
A Survey of Eukaryotic Cells and Microorganisms Part 5 - Page 6

Lecture Note
A Survey of Eukaryotic Cells and Microorganisms Part 5
-
University:
Massachusetts Institute of Technology -
Course:
1.89 | Environmental Microbiology Academic year:
2021
-
Views:
484
Pages:
10
Author:
Charlee Buchanan
Related Documents
Report
Tell us what’s wrong with it:
Thanks, got it!
We will moderate it soon!
Report
Tell us what’s wrong with it:
Free up your schedule!
Our EduBirdie Experts Are Here for You 24/7! Just fill out a form and let us know how we can assist you.
Take 5 seconds to unlock
Enter your email below and get instant access to your document